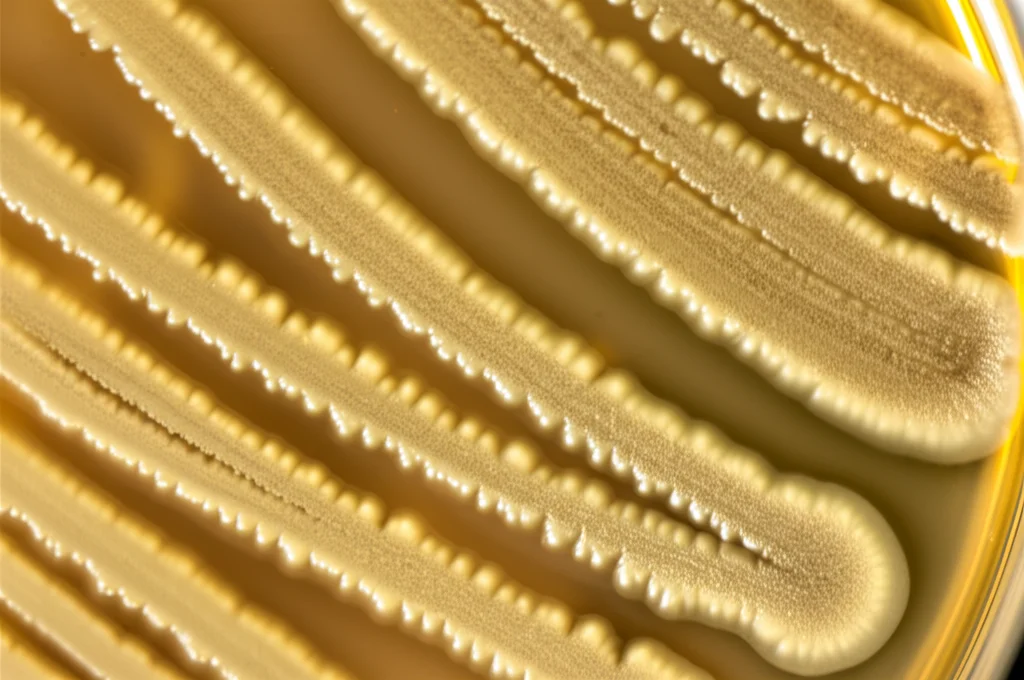
Primo piano di colonie batteriche di Bacillus velezensis Lzh-5 su una piastra di Petri in laboratorio che mostrano un alone di inibizione contro un fungo patogeno (es. Fusarium). Macro lens, 70mm, high detail, precise focusing, controlled lighting, shallow depth of field.

Bacillus Velezensis Lzh-5: Il Super Batterio Amico delle Piante Svela i Suoi Segreti!
Ciao a tutti, appassionati di scienza e natura! Oggi voglio portarvi con me in un viaggio affascinante nel mondo microscopico, alla scoperta di un vero e proprio supereroe del suolo: il Bacillus velezensis Lzh-5. Perché supereroe? Beh, immaginate un piccolo organismo capace non solo di combattere i nemici delle nostre piante, ma anche di aiutarle a crescere più forti e sane. Sembra fantascienza, vero? Eppure, è tutto reale e scritto nel suo DNA!
Le malattie delle piante sono un incubo per chiunque coltivi, dal piccolo orto casalingo alle grandi produzioni agricole. Riducono i raccolti, compromettono la qualità e ci costringono spesso a usare fungicidi chimici. Questi ultimi, però, sappiamo che a lungo andare possono creare problemi: resistenze nei patogeni, rischi per la nostra salute e per l’ambiente. Ecco perché la ricerca di alternative più “verdi” è fondamentale. E qui entra in gioco il nostro Lzh-5!
Un Eroe Nascosto nel Terreno
Questo batterio, isolato da un campione di terreno agricolo a Dezhou, in Cina, appartiene alla grande famiglia dei Bacillus, noti per essere dei veri tuttofare nel mondo microbico. Molti suoi “cugini” sono già usati come biofertilizzanti o biofungicidi. Ma cosa rende speciale Lzh-5? Per scoprirlo, un team di scienziati ha deciso di fare qualcosa di incredibile: leggere l’intero manuale di istruzioni del batterio, ovvero il suo genoma completo.
Pensate al genoma come a un’enorme enciclopedia che contiene tutti i segreti di un organismo. Sequenziarlo significa decifrare ogni singola lettera di quell’enciclopedia. Nel caso di Lzh-5, si tratta di un “libro” principale (il cromosoma circolare) di oltre 4 milioni di lettere (coppie di basi), con un contenuto di GC (un indicatore della composizione del DNA) del 46%, più un piccolo “opuscolo” aggiuntivo (un plasmide circolare) di quasi 9000 lettere. All’interno di questa mole di informazioni, i ricercatori hanno identificato quasi 4000 geni, la stragrande maggioranza dei quali (il 97%!) contiene le istruzioni per costruire proteine, le vere operaie della cellula.
Il Codice Genetico Svelato: Identità Confermata
Prima di tutto, bisognava essere sicuri della sua identità. Distinguere tra specie molto simili come B. velezensis, B. subtilis e B. amyloliquefaciens solo guardandoli al microscopio o con test biochimici tradizionali è un’impresa ardua. Anche l’analisi del gene 16S rRNA, spesso usato come “codice a barre” per i batteri, a volte non basta. Qui la genomica fa la differenza! Analizzando geni specifici (come gyrB, rpoB, rpoD) e confrontando l’intero genoma con quello di altri batteri simili (tramite un’analisi chiamata ANI, Average Nucleotide Identity), è arrivata la conferma: Lzh-5 è senza dubbio un membro della specie Bacillus velezensis. Anzi, ha mostrato una parentela particolarmente stretta con un altro ceppo noto, JS25R.
Armi Segrete Contro i Funghi: Metaboliti Secondari e Enzimi “Taglia-Muro”
Ma veniamo al sodo: come fa Lzh-5 a combattere i funghi cattivi come quelli del genere Fusarium, responsabili di tante malattie delle piante? Il suo genoma ci ha svelato un vero arsenale!
Innanzitutto, Lzh-5 è un produttore eccezionale di metaboliti secondari. Immaginateli come delle molecole speciali, delle “armi chimiche” naturali. Analizzando il DNA, sono stati trovati ben 13 cluster genici dedicati alla loro produzione. Cosa significa? Che Lzh-5 ha le istruzioni per fabbricare diverse sostanze bioattive. Tra queste, spiccano nomi noti agli esperti:
- Fengicina: Potente antifungino.
- Bacillibactina: Sottrae il ferro essenziale ai patogeni, affamandoli.
- Bacillaene, Difficidina, Macrolactina H: Altri antibiotici con attività contro batteri e funghi.
- Surfattina: Un tensioattivo che aiuta il batterio a muoversi e colonizzare superfici, oltre ad avere attività antimicrobica.
- Bacilisina: Un altro composto con proprietà antibiotiche.
La cosa ancora più intrigante? Uno di questi cluster (il numero 2), responsabile della produzione di un composto chiamato fosfonato, sembra essere presente solo in Lzh-5 e nel suo parente stretto JS25R, tra i ceppi confrontati. Questo potrebbe significare che Lzh-5 ha delle armi uniche, forse con uno spettro d’azione ancora più ampio o capaci di colpire bersagli diversi! È una pista caldissima per la scoperta di nuovi composti bioattivi.
Ma non è finita qui! Lzh-5 non si limita a “intossicare” i nemici. Possiede anche gli strumenti per attaccarli fisicamente, degradando le loro pareti cellulari. Il genoma contiene geni per produrre una serie di enzimi CAZymes (Carbohydrate-Active enZymes), tra cui:
- Cellulasi, xilanasi, glucanasi: Degradano componenti della parete cellulare fungina come cellulosa, xilano e glucani.
- Chitinasi e chitosanasi: Attaccano la chitina, un altro componente fondamentale della parete dei funghi.
- Lisozimi: Rompono legami specifici nelle pareti batteriche e fungine.
Molti di questi enzimi sono “secreti”, cioè rilasciati all’esterno della cellula batterica, pronti a colpire i patogeni circostanti. È come avere a disposizione delle forbici molecolari per smontare le difese nemiche!
Un Pollice Verde Batterico: Come Lzh-5 Aiuta le Piante a Crescere
Se pensate che Lzh-5 sia solo un guerriero, vi sbagliate. È anche un incredibile giardiniere! Il suo genoma è pieno di geni che lo rendono un promotore della crescita delle piante (PGP – Plant Growth-Promoting). Vediamo come:
- Colonizzazione delle Radici: Per aiutare una pianta, devi starle vicino! Lzh-5 ha geni per la motilità (costruzione di flagelli, le “code” per nuotare nel terreno) e la chemiotassi (la capacità di percepire le sostanze rilasciate dalle radici e muoversi verso di esse). Una volta arrivato, può formare biofilm, comunità batteriche adese alle radici che le proteggono e facilitano lo scambio di nutrienti. Geni come spo0A, abrB, sinR, epsA-O, tapA-sipW-tasA sono tutti coinvolti in questi processi.
- Nutrizione Potenziata: Azoto (N) e Fosforo (P) sono fondamentali per le piante. Lzh-5, pur non essendo un “fissatore” di azoto atmosferico nel senso classico (mancano i geni nif chiave), possiede geni per assimilare l’azoto presente nel suolo (nitrati, ammonio) e trasportarlo (nas, amt, narK). Inoltre, ha geni per solubilizzare il fosforo “bloccato” nel terreno (fosfatasi alcalina phoAD, trasportatori pstABCS) e per produrre acidi organici che aiutano in questo processo. Rende i nutrienti più disponibili per la pianta!
- Ormoni Vegetali: Lzh-5 potrebbe dare una spinta diretta alla crescita producendo o influenzando gli ormoni vegetali, come l’acido indol-3-acetico (IAA), un’importante auxina. Sono stati trovati geni potenzialmente coinvolti in questa sintesi (es. trpC).
- Resistenza Indotta e Tolleranza allo Stress: Questo batterio produce acetoina e 2,3-butandiolo. Questi composti volatili possono agire come segnali per la pianta, attivando le sue difese interne (resistenza sistemica indotta – ISR) contro futuri attacchi di patogeni o stress ambientali. Inoltre, Lzh-5 ha geni per produrre osmoprotettori come prolina e glicina betaina (betB, trasportatori specifici) e spermidina (speB, speD, speE), che aiutano il batterio (e indirettamente la pianta) a resistere a condizioni difficili come la siccità o l’eccessiva salinità. Produce anche GABA (acido γ-amminobutirrico), che può avere ruoli nella difesa.

Confronto tra Campioni: Unicità e Potenziale
Confrontare il genoma di Lzh-5 con quello di altri ceppi famosi (B. velezensis SQR9, FZB42, JS25R e B. amyloliquefaciens DSM7) è stato illuminante. Tutti condividono un nucleo di circa 3300 geni “essenziali” per la vita da Bacillus. Tuttavia, Lzh-5 possiede anche geni unici (circa 10 geni non trovati negli altri quattro) e una combinazione particolare di cluster per i metaboliti secondari, come il già citato cluster del fosfonato condiviso solo con JS25R. Queste differenze genetiche potrebbero tradursi in capacità uniche, magari una maggiore efficacia contro certi patogeni o una migliore adattabilità a specifici ambienti. È proprio questa diversità che rende lo studio di nuovi ceppi così eccitante!
Verso un’Agricoltura Più Verde
Cosa ci dice tutto questo? Che Bacillus velezensis Lzh-5 è un candidato eccezionale per sviluppare nuovi prodotti per l’agricoltura sostenibile. Ha le carte in regola per essere sia un agente di biocontrollo efficace contro le malattie fungine, sia un biofertilizzante che promuove la crescita delle piante. La sua capacità di produrre composti unici apre anche la porta alla scoperta di nuove molecole bioattive utili magari anche in altri campi.

Avere la mappa completa del suo genoma è come avere la chiave per capire a fondo i suoi meccanismi d’azione e per ottimizzare il suo utilizzo in campo. Certo, la ricerca non si ferma qui. Bisognerà testare Lzh-5 in condizioni reali, capire come interagisce con diverse piante e ambienti, e magari scoprire la funzione di quei geni unici che lo rendono così speciale.
Ma una cosa è certa: nel piccolo grande mondo dei microbi del suolo si nascondono alleati preziosi per un futuro più verde e sostenibile. E Lzh-5 è sicuramente uno di questi! Spero che questo tuffo nella genomica batterica vi abbia affascinato quanto ha affascinato me. Alla prossima scoperta!
Fonte: Springer
